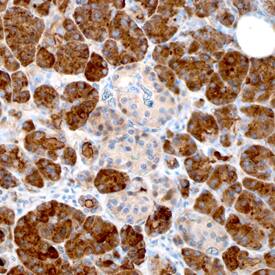
Reg1A antibody in Human Pancreas by Immunohistochemistry (IHC-P).

Human Reg1A/B Antibody
R&D Systems, part of Bio-Techne | Catalog # AF4937


Key Product Details
Species Reactivity
Applications
Label
Antibody Source
Product Specifications
Immunogen
Gln23-Asn166
Accession # P05451
Specificity
Clonality
Host
Isotype
Scientific Data Images for Human Reg1A/B Antibody
Detection of Human Reg1A by Western Blot.
Western blot shows lysates of human pancreas tissue. PVDF membrane was probed with 1 µg/mL of Sheep Anti-Human Reg1A Antigen Affinity-purified Polyclonal Antibody (Catalog # AF4937) followed by HRP-conjugated Anti-Sheep IgG Secondary Antibody (Catalog # HAF016). Specific bands were detected for Reg1A at approximately 20-22 kDa (as indicated). This experiment was conducted under reducing conditions and using Immunoblot Buffer Group 1.Reg1A in Human Pancreas.
Reg1A was detected in immersion fixed paraffin-embedded sections of human pancreas using Sheep Anti-Human Reg1A Antigen Affinity-purified Polyclonal Antibody (Catalog # AF4937) at 3 µg/mL overnight at 4 °C. Before incubation with the primary antibody, tissue was subjected to heat-induced epitope retrieval using Antigen Retrieval Reagent-Basic (Catalog # CTS013). Tissue was stained using the Anti-Sheep HRP-DAB Cell & Tissue Staining Kit (brown; Catalog # CTS019) and counterstained with hematoxylin (blue). Specific staining was localized to cytoplasm in exocrine cells. View our protocol for Chromogenic IHC Staining of Paraffin-embedded Tissue Sections.Applications for Human Reg1A/B Antibody
Immunohistochemistry
Sample: Immersion fixed paraffin-embedded sections of human pancreas
Western Blot
Sample: Human pancreas tissue
Reviewed Applications
Read 1 review rated 4 using AF4937 in the following applications:
Formulation, Preparation, and Storage
Purification
Reconstitution
Formulation
Shipping
Stability & Storage
- 12 months from date of receipt, -20 to -70 °C as supplied.
- 1 month, 2 to 8 °C under sterile conditions after reconstitution.
- 6 months, -20 to -70 °C under sterile conditions after reconstitution.
Background: Reg1A/B
Reg1A (Regenerating gene IA/ alpha; also REG, ICRF, PSPS, PTP and Lithostathine-1 alpha) is a secreted, variably glycosylated 15-22 kDa type I member of the REG gene family of proteins. It is induced in proliferating cell types such as colonic epithelium, islet beta-cells, and multiple tumor types, and is constitutively expressed by pancreatic acinar cells. Thus, Reg1A is found both in blood (ng/mL quantities) and pancreatic secretions. It would appear that Reg1A plays a role in blocking apoptosis, and is upregulated by both IL-22 and IL-6. Human Reg1A is synthesized as a 166 amino acid (aa) precursor. It contains a 22 aa signal sequence plus a 144 aa mature region that is characterized by the presence of three intrachain disulfide bonds, one C-type lectin domain (aa 34-164), and a utilized N-terminal O-linked glycosylation site (Thr27). Variablility in the glycosylation pattern, plus proteolytic cleavage after Arg11 generates Reg1A isoforms in the 15-22 kDa range. There is one potential isoform variant that shows an alternative start site at Met9. Mature (aa 23-166) human Reg1A shares 76% and 69% aa sequence identity with mouse and rat Reg1A, respectively.
Reg1B, also known as secretory pancreatic stone protein 2 and lithostathine 1 beta, is a type I subclass member of the Reg family, which comprises secreted proteins with a C-type lectin domain. Reg1B is highly related to Reg1A, a protein that is implicated in islet cell regeneration and diabetogenesis.Long Name
UniProt
Additional Reg1A/B Products
Product Documents for Human Reg1A/B Antibody
Product Specific Notices for Human Reg1A/B Antibody
For research use only